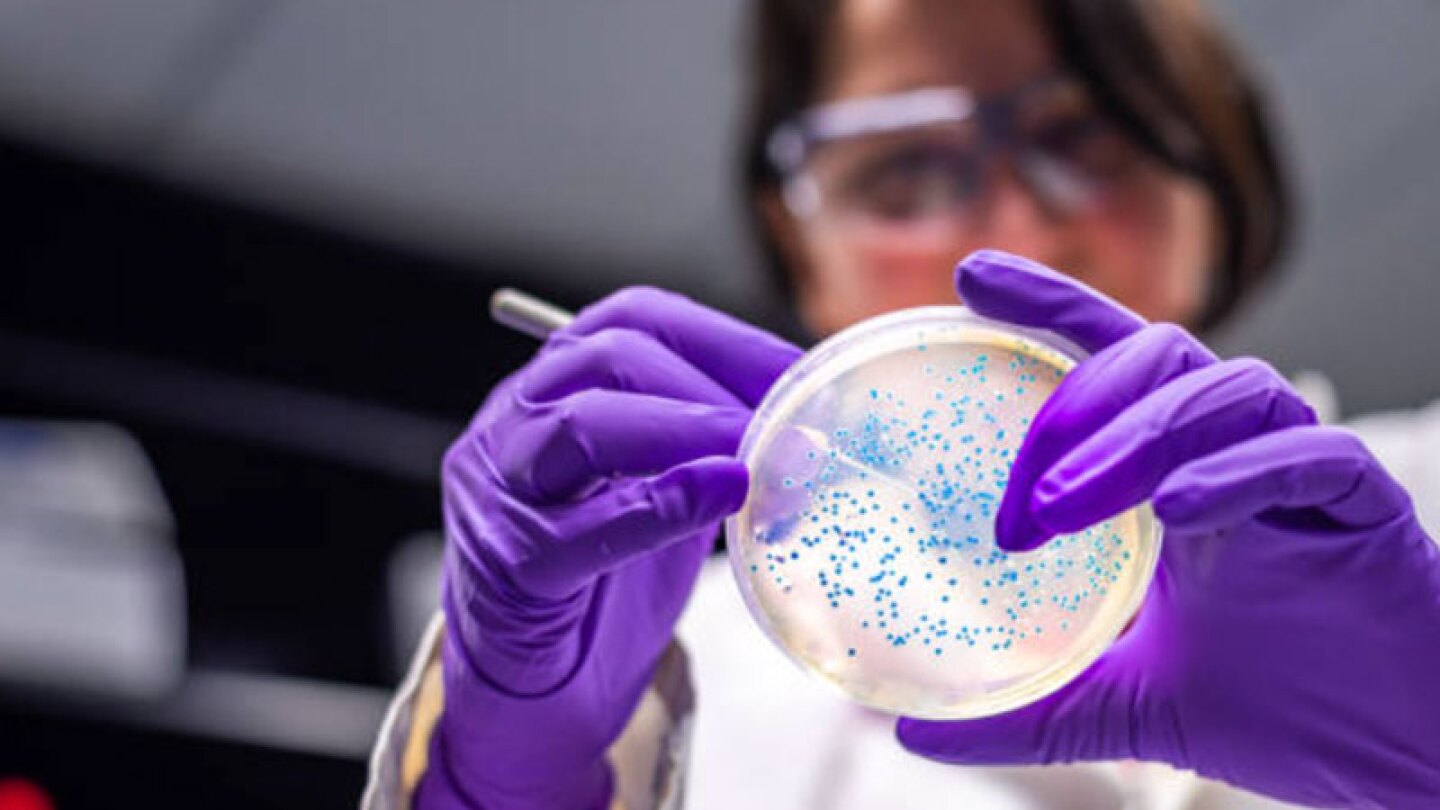

¿Qué es el síndrome de Guillain-Barré? ¿Por qué es peligroso lavar el pollo?
Autoridades de salud en CDMX y Tlaxcala se encuentran en alerta por la presencia del síndrome de Guillain-Barré.
Persona analizando una bacteria
/Pixabay
Las autoridades de Tlaxcala informaron de la muerte de dos personas por el Síndrome de Guillain-Barré, el cual es un trastorno que ataca los nervios.
Cabe señalar que en el estado de Tlaxcala, por este padecimiento, un hombre de 65 años de edad se sumó a otro hombre de 48 años, por lo que las autoridades han hecho un llamado a la población para tener preocupación.
Mira: Semana Santa 2024: Consume atún y no soya, lo dice la PROFECO
¿Qué es el síndrome de Guillain-Barré?
La Organización Mundial de la Salud (OMS) comenta que el síndrome de Guillain-Barré es una enfermedad poco común. Debido a esta situación, no hay información clara sobre cuáles son las situaciones que lo provocan.
El portal Mayo Clinic reveló algunos de los síntomas que tienen las personas que son atacadas por el síndrome de Guillain-Barré, pues informaron que suelen tener debilidad, hormigueo en las manos y los pies, dificultad para respirar, dolor de espalda y de cuello. Además, con el tiempo, puede paralizar todo el cuerpo.
De acuerdo con la Subsecretaría de Prevención y Promoción de la Salud de México, el síndrome de Guillain-Barré puede afectar a cualquier persona y normalmente ocurre después de la presencia de una infección viral respiratoria o gastrointestinal.
El gobierno de Tlaxcala dio a conocer que las posibles causas del síndrome de Guillain-Barré y son: infecciones respitoratorias incluyendo influenza y Covid-19, infecciones gastrointestinales y virus de Zika.
Ve: ¿Cómo cuidar tu mascota de la fuerte ola de calor? ¡Cuidado con el ‘señor sol’!
¿Lavar el pollo puede causar el síndrome de Guillain-Barré?
Aunque no hay certeza de que el pollo cause el síndrome de Guillain-Barré, la OMS informó que lavar el pollo aumenta el riesgo de contraer Salmonela, Campylobacter y otras bacterias dañinas.
La OMS informó que lavar el pollo puede dispersar estas bacterias por toda la cocina, por lo que puede contaminar los utensilios y otros alimentos que estén cerca, aumentando el riesgo de infección.
Es por eso que recomienda cocinar el pollo a una temperatura interna segura de 74 °C, esto elimina la bacteria Campylobacter jejuni, por lo que no es necesario lavarlo previamente.
Checa: ¿Cómo hacer un tónico de romero para hacer crecer el cabello?
Lavarse las manos con agua y jabón luego de manipular el pollo. Cabe señalar que el síndrome de Guillain-Barré es poco común, por lo que las personas que se infectan con la bacteria Campylobacter jejuni no desarrollan este síndrome.
Debido al incremento del síndrome de Guillain-Barré, las autoridades de Tlaxcala y la Secretaría de Salud estatal emitieron algunas recomendaciones con el fin de prevenir más casos, por lo cual recomiendan:
- Lavarse las manos.
- Lavar y desinfectar las frutas y verduras.
- Comer carnes bien cocidas.
- Evitar el consumo de alimentos en lugares de dudosa higiene.
- Usar repelentes para evitar picaduras de mosquitos.